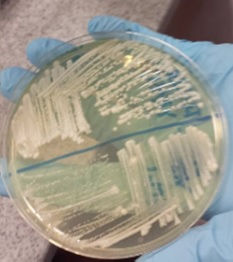

top of page

"Als ik zou moeten laten zien hoe je een Meesterproef doet, dan laat ik jullie eindverslag zien." "Goed vooronderzoek en diepgang zeker aanwezig."~Rutger Gast
Portfolio
Angela Gankema
"Je hebt de bijbel van dit practicum geschreven." "Als ik mijn eigen lab zou hebben zou ik je alvast vast willen leggen voor je bachelorstage, heel goed gedaan!!" ~Practicumbegeleider Genetica en Evolutie
Hoi allemaal, welkom op mijn portfolio. Ik ben Angela Gankema en ik ben 22 jaar. Ik heb op het Technasium op het Calandlyceum in Amsterdam gezeten en studeer nu Biomedical Sciences aan de Universiteit van Amsterdam. Dit is mijn portfolio met o.a. de projecten die ik op het Technasium gedaan heb. Verder kunt u in mijn portfolio mijn werkplekken, ervaringen, sporten en vrijwilligerswerk terugvinden. Veel leesplezier!
bottom of page